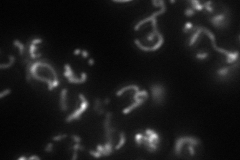
YER073W
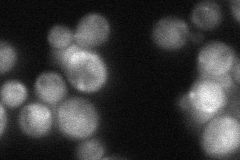
YER073W

View description
Mitochondrial aldehyde dehydrogenase, involved in regulation or biosynthesis of electron transport chain components and acetate formation; activated by K+; utilizes NADP+ as the preferred coenzyme; constitutively expressed
Localization:
Intensity:
Fold change:
Significance:
-
C’ GFP library in SD

mitochondria171.79 -
N' NOP1pr-GFP in SD

mitochondria46.8673 -
N' TEF2pr-mCherry in SD
mitochondria65.7314 -
N' NATIVEpr-GFP in SD
cytosol,punctate48.7387 -
N' TEF2pr-VC and Cyto-VN in SD

#N/A0 -
C’ GFP library in SD+DTT

mitochondria149.870.87No -
C’ GFP library in SD+H2O2

mitochondria169.820.98No -
C’ GFP library in Starvation Media

mitochondria105.920.61No -
C’ GFP library on the background of Pup2-DaMP

mitochondria -
C’ GFP library on the background of CCT mutant

mitochondria177.1781.0313No
